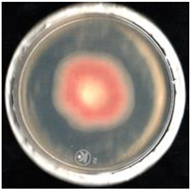
Agronomy 11 01098 i006
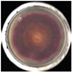
Agronomy 11 01098 i013
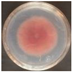
Agronomy 11 01098 i021
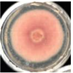
Agronomy 11 01098 i023
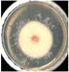
Agronomy 11 01098 i029

In Vitro Antifungal Activity and Chemical Composition of Piper auritum Kunth Essential Oil against Fusarium oxysporum and Fusarium equiseti
Abstract
:1. Introduction
2. Materials and Methods
2.1. Plant Material and Essential Oil
2.2. Direct Analysis in Real Time Mass Spectrometry (DART-MS)
2.3. Fusarium Strains
2.4. Mycelium Disk Microdiffusion Assay
2.5. Poisoned Food Assay
2.6. MGI and MIC50 Determination
2.7. Statistical Analysis
3. Results
3.1. Aerial Part Essential Oil of P. auritum
3.2. Mass Spectrometry by Direct Analysis in Real-Time (DART-MS)
3.3. Antifungal Activity of Essential Oil
3.3.1. Mycelium Disc Microdiffusion Assay
3.3.2. Poisoned Food Assay
3.3.3. MGI and MIC50 Determination
4. Discussion
5. Conclusions
Author Contributions
Funding
Institutional Review Board Statement
Informed Consent Statement
Data Availability Statement
Acknowledgments
Conflicts of Interest
References
- Li, X.; de Boer, W.; Zhang, Y.; Ding, C.; Zhang, T.; Wang, X. Suppression of soil-borne Fusarium pathogens of peanut by intercropping with the medicinal herb Atractylodes lancea. Soil Biol. Biochem. 2018, 116, 120–130. [Google Scholar] [CrossRef]
- Orobiyi, A.; Dansi, A.; Assogba, P.; Loko, L.Y.; Dansi, M.; Vodouhè, R.; Akouègninou, A.; Sanni, A. Chili (Capsicum annuum L.) in southern Benin: Production constraints, varietal diversity, preference criteria and participatory evaluation. Int. Res. J. Agric. Sci. Soil Sci. 2013, 3, 107–120. [Google Scholar]
- Shafique, S.; Shafique, S.; Ahmad, A. Biochemical and molecular screening of varieties of chili plants that are resistant against Fusarium wilt infection. Eur. J. Microbiol. Immunol. 2018, 8, 12–19. [Google Scholar] [CrossRef]
- Ridzuan, R.; Rafii, M.Y.; Ismail, S.I.; Yusoff, M.M.; Miah, G.; Usman, M. Breeding for anthracnose disease resistance in chili: Progress and prospects. Int. J. Mol. Sci. 2018, 19, 3122. [Google Scholar] [CrossRef] [Green Version]
- Van Zonneveld, M.; Ramirez, M.; Williams, D.E.; Petz, M.; Meckelmann, S.; Avila, T.; Bejarano, C.; Ríos, L.; Peña, K.; Jäger, M.; et al. Screening genetic resources of Capsicum peppers in their primary center of diversity in Bolivia and Peru. PLoS ONE 2015, 10, e134663. [Google Scholar] [CrossRef]
- Madbouly, A.K.; Abdelbacki, A.M.M. Biocontrol of certain soilborne diseases and promotion of growth of Capsicum annuum using biofungicides. Pak. J. Bot. 2017, 49, 371–378. [Google Scholar]
- Jaber, L.R.; Alananbeh, K.M. Fungal entomopathogens as endophytes reduce several species of Fusarium causing crown and root rot in sweet pepper (Capsicum annuum L.). Biol. Control 2018, 126, 117–126. [Google Scholar] [CrossRef]
- Velarde-Félix, S.; Garzón-Tiznado, J.A.; Hernández-Verdugo, S.; López-Orona, C.A.; Retes-Manjarrez, J.E. Occurrence of Fusarium oxysporum causing wilt on pepper in Mexico. Can. J. Plant Pathol. 2018, 41, 238–247. [Google Scholar] [CrossRef]
- Rivera-Jiménez, M.N.; Zavaleta-Mancera, H.A.; Rebollar-Alviter, A.; Aguilar-Rincón, V.H.; García-de-los-Santos, G.; Vaquera-Huerta, H.; Silva-Rojas, H.V. Phylogenetics and histology provide insight into damping-off infections of ‘Poblano’ pepper seedlings caused by Fusarium wilt in greenhouses. Mycol Progress 2018, 17, 1237–1249. [Google Scholar] [CrossRef]
- Gilardi, G.; Pintore, I.; Gullino, M.L.; Garibaldi, A. Occurence of Fusarium equiseti as a contaminant of Diplotaxis tenuifolia seeds. J. Plant Pathol. 2017, 99, 245–248. [Google Scholar] [CrossRef]
- Bhat, M.N.; Mesta, R.; Yenjerappa, S.T.; Tatagar, M.H.; Sardana, H.R.; Singh, D.; Vennila, S.; Sabir, N.; Ahmad, M. Biological control of Fusarium wilt of chillies using Trichoderma spp. Indian J. Hort. 2016, 73, 74–77. [Google Scholar] [CrossRef]
- Mdee, L.; Masoko, P.; Eloff, J. The activity of extracts of seven common invasive plant species on fungal phytopathogens. S. Afr. J. Bot. 2009, 75, 375–379. [Google Scholar] [CrossRef] [Green Version]
- Cespedes, C.L.; Alarcon, J.; Aqueveque, P.M.; Lobo, T.; Becerra, J.; Balbontin, C.; Avila, J.G.; Kubo, I.; Seigler, D.S. New environmentally-friendly antimicrobials and biocides from andean and mexican biodiversity. Environ. Res. 2015, 142, 549–562. [Google Scholar] [CrossRef] [PubMed]
- Zakuan, Z.; Mustapa, S.A.; Sukor, R.; Rukayadi, Y. Antifungal activity of Boesenbergia rotunda (temukunci) extract against filamentous spoilage fungi from vegetables. Int. Food Res. J. 2018, 25, 433–438. [Google Scholar]
- Ray, A.; Jena, S.; Dash, B.; Kar, B.; Halder, T.; Chatterjee, T.; Ghosh, B.; Panda, P.C.; Nayak, S.; Mahapatra, N. Chemical diversity, antioxidant and antimicrobial activities of the essential oils from Indian populations of Hedychium coronarium Koen. Ind. Crop. Prod. 2018, 112, 353–362. [Google Scholar] [CrossRef]
- Salem, M.Z.M.; Zidan, Y.E.; Mansour, M.M.A.; El Hadidi, N.M.N.; Abo Elgat, W.A.A. Antifungal activities of two essential oils used in the treatment of three commercial woods deteriorated by five common mold fungi. Int. Biodeterior. Biodegrad. 2016, 106, 88–96. [Google Scholar] [CrossRef]
- Hao, C.Y.; Fan, R.; Qin, X.W.; Hu, L.S.; Tan, L.H.; Xu, F.; Wu, B.D. Characterization of volatile compounds in ten Piper species cultivated in Hainan Island, South China. Int. J. Food Prop. 2018, 21, 633–644. [Google Scholar] [CrossRef] [Green Version]
- Granados-Echegoyen, C.; Pérez-Pacheco, R.; Bautista-Martínez, N.; Alonso-Hernández, N.; Sánchez-García, J.A.; Martinez-Tomas, S.H.; Sánchez-Mendoza, S. Insecticidal effect of botanical extracts on developmental stages of Bactericera cockerelli (Sulc) (Hemiptera: Triozidae). Southwest. Entomol. 2015, 40, 97–110. [Google Scholar] [CrossRef]
- Vizcaíno-Páez, S.; Pineda, R.; García, C.; Gil, J.; Durango, D. Metabolism and antifungal activity of saffrole, dillapiole, and derivatives against Botryodliplodia theobromae and Colletotrichum acutatum. Bol. Latinoam. Caribe Plantas Med. Aromat. 2016, 15, 1–17. [Google Scholar]
- Duarte, Y.; Pino, O.; Infante, D.; Sánchez, Y.; Travieso, M.; Martínez, B. Efecto in vitro de aceites esenciales sobre Alternaria solani Sorauer. Rev. Prot. Veg. 2013, 28, 54–59. [Google Scholar]
- Duarte, Y.; Pino, O.; Martínez, B. Effect of four essential oils on phytopathogenic fungi associated with spotted rains in rice. Rev. Prot. Veg. 2014, 29, 62–65. [Google Scholar]
- Duarte, Y.; Pino, O.; Martínez, B. Efecto de cuatro aceites esenciales sobre Fusarium spp. Rev. Prot. Veg. 2013, 28, 232–235. [Google Scholar]
- Chacón, C.; Miranda-Granados, J.; Ruiz-Lau, N.; Lagunas-Rivera, S.; Ruíz-Valdiviezo, V.M.; Gutiérrez-Miceli, F.A. Antifungal activity of extracts from hierba santa (Piper auritum) and jarilla (Baccharis glutinosa) against Fusarium spp. Agrociencia 2020, 54, 531–538. [Google Scholar] [CrossRef]
- Besten, M.A.; Jasinski, V.C.G.; Costa, A.G.L.C.; Nunes, D.S.; Sens, S.L.; Wisniewski, A., Jr.; Simionatto, E.L.; Riva, D.; Dalmarco, J.B.; Granato, D. Chemical composition similarity between the essential oils isolated from male and female specimens of each five Baccharis species. J. Braz. Chem. Soc. 2012, 23, 1041–1047. [Google Scholar] [CrossRef] [Green Version]
- Nefzi, A.; Abdallah, R.A.B.; Jabnoun-Khiareddine, H.; Ammar, N.; Medimagh-Saïdana, S.; Haouala, R.; Daami-Remadi, M. Management of Fusarium crown and root rot of tomato by Solanum linnaeanum L. extracts. Sci. Hortic. 2018, 238, 204–214. [Google Scholar] [CrossRef]
- Procacci, S.; Bojórquez-Quintal, E.; Platamone, G.; Maccioni, O.; Lo Vecchio, V.; Morreale, V.; Alisi, C.; Balducchi, R.; Bacchetta, L. Opuntia ficus-indica pruning waste recycling: Recovery and characterization of mucilage from cladodes. Nat. Resour. 2021, 12, 91–107. [Google Scholar] [CrossRef]
- Miranda-Granados, J.; Chacón, C.; Ruiz-Lau, N.; Vargas-Díaz, M.E.; Zepeda, L.G.; Alvarez-Gutiérrez, P.; Meza-Gordillo, R.; Lagunas-Rivera, S. Alternative use of extracts of chipilín leaves (Crotalaria longirostrata Hook. & Arn) as antimicrobial. Sustainability 2018, 10, 883. [Google Scholar] [CrossRef] [Green Version]
- Buitimea-Cantúa, G.V.; Rosas-Burgos, E.C.; Cinco-Moroyoqui, F.J.; Burgos-Hernández, A.; Plascencia-Jatomea, M.; Cortez-Rocha, M.O.; Gálvez-Ruiz, J.C. In vitro effect of antifungal fractions from the plants Baccharis glutinosa and Jacquinia macrocarpa on chitin and β-1,3-glucan hydrolysis of maize phytopathogenic fungi and on the fungal Β-1,3-glucanase and chitinase activities. J. Food Saf. 2013, 33, 526–535. [Google Scholar] [CrossRef]
- Frías-Escalante, M.P.; Burgos-Hernández, A.; Plascencia-Jatomea, M.; Aldana-Madrid, M.L.; Cortez-Rocha, M.O. Antifungal, acute toxicity and mutagenicity activity of extracts from Datura stramonium, Jacquinia macrocarpa and Krameria erecta on Fusarium verticillioides. Afr. J. Biotechnol. 2015, 14, 2251–2257. [Google Scholar] [CrossRef] [Green Version]
- Medina-López, C.F.; Plascencia-Jatomea, M.; Cinco-Moroyoqui, F.J.; Yépiz-Gómez, M.S.; Cortez-Rocha, M.O.; Rosas-Burgos, E.C. Potentiation of antifungal effect of a mixture of two antifungal fractions obtained from Baccharis glutinosa and Jacquinia macrocarpa plants. J. Environ. Sci. Health B 2016, 51, 760–768. [Google Scholar] [CrossRef]
- Silva, J.L.; Souza, P.E.; Monteiro, F.P.; Freitas, M.L.O.; Silva Júnior, M.B.; Belan, L.L. Antifungal activity using medicinal plant extracts against pathogens of coffee tree. Rev. Bras. Plantas Med. 2014, 16, 539–544. [Google Scholar] [CrossRef] [Green Version]
- Avila-Sosa, R.; Gastélum-Reynoso, G.; García-Juárez, M.; Meneses-Sánchez, M.C.; Navarro-Cruz, A.R.; Dávila-Márquez, R.M. Evaluation of different mexican plant extracts to control anthracnose. Food Bioprocess Technol. 2011, 4, 655–659. [Google Scholar] [CrossRef]
- Pineda, R.M.; Vizcaíno, S.P.; García, C.M.P.; Gil, J.H.G.; Durango, D.L.R. Chemical composition and antifungal activity of Piper auritum Kunth and Piper holtonii C. DC. against phytopathogenic fungi. Chil. J. Agric. Res. 2012, 72, 507–515. [Google Scholar] [CrossRef]
- Rosas-Burgos, E.C.; Cortez-Rocha, M.O.; Cinco-Moroyoqui, F.J.; Robles-Zepeda, R.E.; López-Cervantes, J.; Sánchez-Machado, D.I.; Lares-Villa, F. Antifungal activity in vitro of Baccharis glutinosa and Ambrosia confertiflora extracts on Aspergillus flavus, Aspergillus parasiticus and Fusarium verticillioides. World. J. Microbiol. Biotechnol. 2009, 25, 2257–2261. [Google Scholar] [CrossRef]
- Li, R.; Yang, J.-j.; Wang, Y.-f.; Sun, Q.; Hu, H.-b. Chemical composition, antioxidant, antimicrobial and anti-inflammatory activities of the stem and leaf essential oils from Piper flaviflorum from Xishuangbanna, SW China. Nat. Prod. Commun. 2014, 9, 1011–1014. [Google Scholar] [CrossRef] [PubMed] [Green Version]
- Da Silva, J.K.R.; Silva, J.R.A.; Nascimento, S.B.; Da Luz, S.F.M.; Meireles, E.N.; Alves, C.N.; Ramos, A.R.; Maia, J.G.S. Antifungal activity and computational study of constituents from Piper divaricatum essential oil against Fusarium infection in black pepper. Molecules 2014, 19, 17926–17942. [Google Scholar] [CrossRef] [Green Version]
- Conde-Hernández, L.A.; Espinosa-Victoria, J.R.; Guerrero-Beltrán, J.A. Supercritical extraction of essential oils of Piper auritum and Porophyllum ruderale. J. Supercrit. Fluid. 2017, 127, 97–102. [Google Scholar] [CrossRef]
- Scalvenzi, L.; Yaguache-Camacho, B.; Cabrera-Martínez, P.; Guerrini, A. In vitro antifungal activity of essential oils of Ocotea quixos (Lam.) Kosterm. and Piper aduncum L. Bioagro 2016, 28, 39–46. [Google Scholar]
- Moghaddam, M.; Mehdizadeh, L.; Najafgholi, H.M.; Pirbalouti, A.G. Chemical composition, antibacterial and antifungal activities of seed essential oil of Ferulago angulata. Int. J. Food Prop. 2018, 21, 173–185. [Google Scholar] [CrossRef] [Green Version]
- Salehi, B.; Zakaria, Z.A.; Gyawali, R.; Ibrahim, S.A.; Rajkovic, J.; Shinwari, Z.K.; Khan, T.; Sharifi-Rad, J.; Ozleyen, A.; Turkdonmez, E.; et al. Piper species: A comprehensive review on their phytochemistry, biological activities and applications. Molecules 2019, 24, 1364. [Google Scholar] [CrossRef] [Green Version]
- Mendoza-García, E.E.; Ortega-Arenas, L.D.; Pérez-Pacheco, R.; Rodríguez-Hernández, C. Repellency, toxicity, and oviposition inhibition of vegetable extracts against greenhouse whitefly Trialeurodes vaporariorum (Westwood) (Hemiptera: Aleyrodidae). Chil. J. Agric. Res. 2014, 74, 41–48. [Google Scholar] [CrossRef] [Green Version]
- Conde-Hernández, L.A.; Guerrero-Beltrán, J.A. Total phenolics and antioxidant activity of Piper auritum and Porophyllum ruderale. Food Chem. 2014, 142, 455–460. [Google Scholar] [CrossRef]
- Rodríguez-Chaves, D.; Bagnarello-Madrigal, V.; Alpizar-Cordero, J.; Calvo-Vargas, A.; Cordero-Villalobos, M.; Chinchilla-Carmona, M.; Valerio-Campos, I.; Sánchez-Porras, R. Anti-Leishmania (Trypanosomatidae) activity of trans-Z-α-bisabolene epoxide and isolation of safrole, in fruits of Piper auritum (Piperaceae). Rev. Biol. Trop. 2018, 66, 826–835. [Google Scholar] [CrossRef] [Green Version]
- Tangarife-Castaño, V.; Correa-Royero, J.B.; Roa-Linares, V.C.; Pino-Benitez, N.; Betancur-Galvis, L.A.; Durán, D.C.; Stashenko, E.E.; Mesa-Arango, A.C. Anti-dermatophyte, anti-Fusarium and cytotoxic activity of essential oils and plant extracts of Piper genus. J. Essent. Oil Res. 2014, 26, 221–227. [Google Scholar] [CrossRef]
- Caballero-Gallardo, K.; Olivero-Verbel, J.; Pino-Benítez, N.; Stashenko, E.E. Chemical composition and bioactivity of Piper auritum and P. multiplinervium essential oils against the red flour beetle, Tribolium castaneum (Herbst). Bol. Latinoam. Caribe Plantas Med. Aromat. 2014, 13, 10–19. [Google Scholar]
- Singh, S.; Kapoor, I.P.S.; Singh, G.; Schuff, C.; De Lampasona, M.P.; Catalan, C.A.N. Chemistry, antioxidant and antimicrobial potentials of white pepper (Piper nigrum L.) essential oil and oleoresins. Proc. Natl. Acad. Sci. India Sect. B Biol. Sci. 2013, 83, 357–366. [Google Scholar] [CrossRef]
- Vieira, R.; Severino, P.; Nalone, L.A.; Souto, S.B.; Silva, A.M.; Lucarini, M.; Durazzo, A.; Santini, A.; Souto, E.B. Sucupira Oil-Loaded Nanostructured Lipid Carriers (NLC): Lipid Screening, Factorial Design, Release Profile, and Cytotoxicity. Molecules 2020, 25, 685. [Google Scholar] [CrossRef] [Green Version]
- Correa-Pacheco, Z.C.; Bautista-Baños, S.; Hernández-López, M.; Marquina-Valle, M.A. Evaluation of nanoformulations on in vitro development of fungal phytopathogens. Rev. Mex. Fitopatol. 2018, 36, 457–467. [Google Scholar] [CrossRef] [Green Version]


| Parameter | Found Value |
|---|---|
| Yield | 2.20% (w/w) 1 |
| Density | 0.93 g/mL |
| Dynamic viscosity | 0.81 mPa·s |
| Kinematic viscosity | 0.87 mm2/s |
| Identification | [M-H]− | [M-H+O2]− | [2M-H]− |
|---|---|---|---|
| Thymol | 149.0308 1 | 299.0773 | |
| Eugenol | 163.0181 | 327.0462 | |
| Cymeno | 165.0216 | ||
| Z3,Z6,E8-dodecatrien-1-ol | 179.0047 | ||
| Safrole | 193.0237 | ||
| Palmitic acid | 255.1757 |
| Suggested Metabolite | Molecular Formula (M) | Adduct Ion | m/z Value |
|---|---|---|---|
| Terpenes | |||
| Thymol/p-cymen-8-ol | C10H14O | [M-H]− | 149.0308 1 |
| MW: 150.1044 g/mol | [2M-H]− | 299.0694 | |
| Cymeno (o, p, m) | C10H14 | [M-H+O2]− | 165.0216 |
| MW: 134.1095 g/mol | |||
| Phenylpropanoids | |||
| Eugenol | C10H12O2 | [M-H]− | 163.0181 1 |
| MW: 164.08373 g/mol | [2M-H]− | 327.0462 | |
| Safrole | C10H10O2 | [M+Cl]− | 179.0004 |
| MW: 162.0680 g/mol | [M-H+O2]− | 193.0237 | |
| Alcohols | |||
| Z3,Z6,E8-dodecatrien-1-ol | C10H20O | [M-H]− | 179.0047 |
| MW: 180.1514 g/mol | |||
| Ketones or aldehydes | |||
| 4-hydroxy-4-methyl-2-pentanone | C6H12O2 | [M-H]− | 115.0495 |
| MW:116.0837 g/mol | [2M-H]− | 231.0744 | |
| 2-hexenal | C6H10O | [M-OH]− | 115.0495 |
| MW:98.0731 g/mol | |||
| Esters | |||
| Methyl 2,4-decadienoate | C11H18O2 | [M-H]− | 181.0234 |
| MW:182.1306 | [M-OH]− | 199.0508 | |
| Fatty acids | |||
| Palmitic acid/Hexadecanoic acid | C16H32O2 | [M-H]− | 255.1757 |
| MW:256.2402 g/mol | |||
| Alkanes | |||
| Tetradecane | C14H30 | [M-H]− | 197.0267 |
| MW:198.2347 g/mol | [M+Cl]− | 233.1018 |
| Treatment | FCHJ-T6 | FCHA-T7 | FCHE-T8 |
|---|---|---|---|
| H2O (−) |  0.0 ± 0.0c |  0.0 ± 0.0c |  0.0 ± 0.0c |
| EOFS |  63.4 ± 3.2b |  60.7 ± 4.3b | 42.1 ± 2.8b |
| SPK (+) |  99.6 ± 0.4a |  99.6 ± 0.4a |  99.2 ± 0.4a |
| Treatment | FCHJ-T6 | FCHA-T7 | FCHE-T8 |
|---|---|---|---|
| H2O (−) |  0.0 ± 0.0e |  0.0 ± 0.0d |  0.0 ± 0.0f |
| EO-0.1 | 1.2 ± 1.4e |  1.1 ± 0.7d |  29.7 ± 0.8de |
| EO-0.2 |  4.4 ± 1.1e |  1.1 ± 0.0d |  37.8 ± 2.8cd |
| EO-0.4 |  5.2 ± 0.4e |  2.3 ± 0.7d | 20.3 ± 0.8e |
| EO-3.0 |  23.3 ± 0.4d | 17.1 ± 1.1c |  34.7 ± 2.0d |
| EO-5.0 |  41.4 ± 2.9c |  22.7 ± 3.3c |  46.4 ± 3.3bc |
| EO-8.4 |  57.8 ± 7.4b | 42.4 ± 3.6b |  55.9 ± 2.7b |
| SPK (+) |  98.8 ± 0.0a |  100.0 ± 0.0a |  98.2 ± 1.2a |
| Fungal Strains | MIC50 | MGI |
|---|---|---|
| FCHJ-T6 | 9 mg/mL | |
| FCHA-T7 | 6 mg/mL | 9 mg/mL |
| FCHE-T8 | 9 mg/mL | |
Publisher’s Note: MDPI stays neutral with regard to jurisdictional claims in published maps and institutional affiliations. |
© 2021 by the authors. Licensee MDPI, Basel, Switzerland. This article is an open access article distributed under the terms and conditions of the Creative Commons Attribution (CC BY) license (https://creativecommons.org/licenses/by/4.0/).
Share and Cite
Chacón, C.; Bojórquez-Quintal, E.; Caamal-Chan, G.; Ruíz-Valdiviezo, V.M.; Montes-Molina, J.A.; Garrido-Ramírez, E.R.; Rojas-Abarca, L.M.; Ruiz-Lau, N. In Vitro Antifungal Activity and Chemical Composition of Piper auritum Kunth Essential Oil against Fusarium oxysporum and Fusarium equiseti. Agronomy 2021, 11, 1098. https://doi.org/10.3390/agronomy11061098
Chacón C, Bojórquez-Quintal E, Caamal-Chan G, Ruíz-Valdiviezo VM, Montes-Molina JA, Garrido-Ramírez ER, Rojas-Abarca LM, Ruiz-Lau N. In Vitro Antifungal Activity and Chemical Composition of Piper auritum Kunth Essential Oil against Fusarium oxysporum and Fusarium equiseti. Agronomy. 2021; 11(6):1098. https://doi.org/10.3390/agronomy11061098
Chicago/Turabian StyleChacón, César, Emanuel Bojórquez-Quintal, Goretty Caamal-Chan, Víctor M. Ruíz-Valdiviezo, Joaquín A. Montes-Molina, Eduardo R. Garrido-Ramírez, Luis M. Rojas-Abarca, and Nancy Ruiz-Lau. 2021. "In Vitro Antifungal Activity and Chemical Composition of Piper auritum Kunth Essential Oil against Fusarium oxysporum and Fusarium equiseti" Agronomy 11, no. 6: 1098. https://doi.org/10.3390/agronomy11061098








